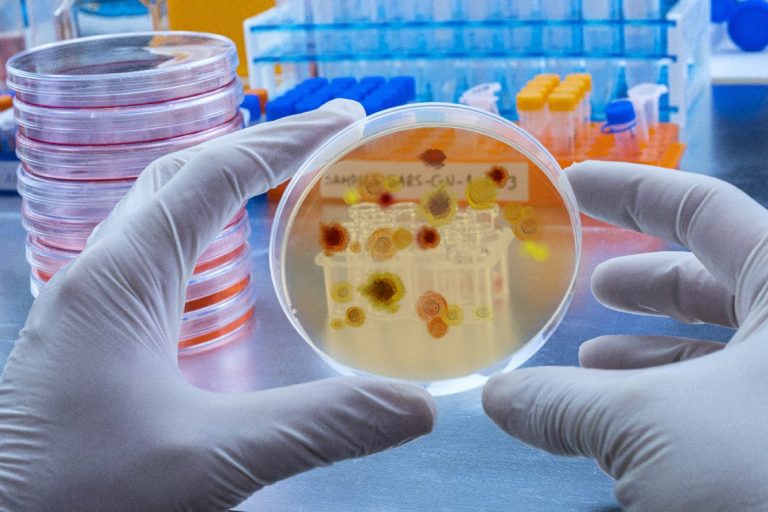

SERVICIOS
Nuestros clientes más destacados
DIGICOMPHOTO produce y crea imágenes impactantes. Nuestra misión es fortalecer su imágen corporativa a través de fotografías profesionales que capturan los valores y la visión de su empresa.
FOTOGRAFIA ARQUITECTURA
PRODUCCIÓN FOTOGRÁFICA ESPECIALIZADA
FOTOGRAFÍA COMERCIAL Y DE PRODUCTO
FOTOGRAFÍA CIENCIA Y MEDICINA
BANCOS IMÁGEN
VIDEO EN HD / 4K
COMO TRABAJAMOS CONTIGO
¿Qué necesito para elaborar
un presupuesto?
¿Cuáles son los plazos de entrega?
Trabajamos en estrecha colaboración con nuestros clientes para establecer un calendario que se ajuste a sus necesidades.
Los plazos de entrega y visualización del master dependen de la complejidad de cada sesión, permisos necesarios, cantidad de imágenes y nivel de edición necesario.
Para llevar a cabo un proyecto de fotografía en DIGICOMPHOTO, es fundamental contar con un presupuesto personalizado que detalle el número de imágenes requeridas y los recursos necesarios. Este enfoque garantiza que se ajusten las tarifas precisas a las necesidades específicas del proyecto.
Además, es crucial conocer con antelación las expectativas y requerimientos del estudio, lo que facilita una planificación efectiva y maximiza la calidad de los resultados obtenidos.
¿Cómo se entregan los trabajos terminados?
¿ Necesito alguna documentación especial ?
La respuesta es si. Siempre que elaboramos algún trabajo sobre fotografía, necesitamos un documento de consentimiento y confidencialidad. Es necesario para proteger la identidad corporativa del cliente, ya que lo primero que pensamos es en su identidad como cliente satisfecho.
Si se necesitara algún permiso MR ( Model Release ) éste se cumplimentaría sin ningún problema, es sólo un trámite de imágen.
La razón fundamental es conseguir que nuestro trabajo sea su exclusividad.
Las imágenes se entregan en formato JPEG a una resolución de 300 dpi. Puede elegir la forma de recibir éstas, en formato rígido o descarga en la nube.
Las imágenes estarán listas para ser utilizadas en diversas plataformas, desde tiendas online hasta material impreso o redes sociales.